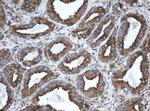
EPHX1 Antibody in Immunohistochemistry (Paraffin) (IHC (P))

Search
OriGene
EPHX1 Monoclonal Antibody (OTI3F10), TrueMAB™
{{$productOrderCtrl.translations['antibody.pdp.commerceCard.promotion.promotions']}}
{{$productOrderCtrl.translations['antibody.pdp.commerceCard.promotion.viewpromo']}}
{{$productOrderCtrl.translations['antibody.pdp.commerceCard.promotion.promocode']}}: {{promo.promoCode}} {{promo.promoTitle}} {{promo.promoDescription}}. {{$productOrderCtrl.translations['antibody.pdp.commerceCard.promotion.learnmore']}}
产品信息
TA800407
种属反应
宿主/亚型
分类
类型
克隆号
抗原
偶联物
形式
浓度
纯化类型
保存液
内含物
保存条件
运输条件
靶标信息
Biotransformation enzyme that catalyzes the hydrolysis of arene and aliphatic epoxides to less reactive and more water soluble dihydrodiols by the trans addition of water. May play a role in the metabolism of endogenous lipids such as epoxide-containing fatty acids.
仅用于科研。不用于诊断过程。未经明确授权不得转售。
篇参考文献 (0)
生物信息学
蛋白别名: Epoxide hydratase; Epoxide hydrolase 1; epoxide hydrolase 1 (microsomal xenobiotic hydrolase); epoxide hydrolase 1 microsomal; epoxide hydrolase 1, microsomal (xenobiotic); liver microsomal xenobiotic epoxide hydrolase; mEH; Microsomal epoxide hydrolase
基因别名: AI195553; Eph-1; Eph1; EPHX; EPHX1; EPOX; Epxh1; HYL1; MEH; MEH8
UniProt ID: (Human) P07099, (Rat) P07687, (Mouse) Q9D379
Entrez Gene ID: (Human) 2052, (Rat) 25315, (Mouse) 13849